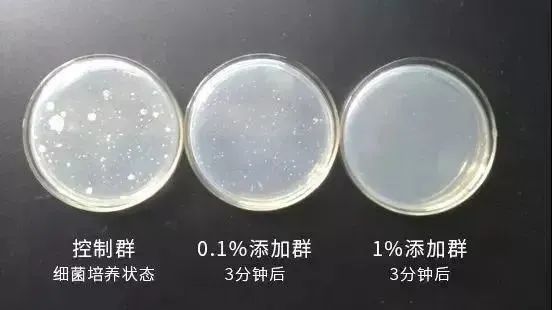

老公以前脾胃很差
经常胃胀,一受寒也会痛
疼的时候他都默默忍着

而且他还口臭
没办法和他近距离接触

因为担心,我也让他去检查一下
他去做胃镜
想呕不能呕,那感觉生不如死...

查了一圈只说是慢性胃炎!

可最近这段时间
他经常在家大鱼吃肉
吃完没有哭天喊地说痛
消化的也比之前好一些
口臭也有所改善

而且他舌头上的厚腻也消减了
齿痕也少了

没来得及问他怎么调理的
今天看他在喝茶,问他是什么,他说是饮料
就是下面这个
↓↓↓

原来他喝的这个是南京同仁堂出品的
【丁香汇苓饮】
是一款纯植物提取的固体饮料
属食疗范围,是专为
胃疼 l 胃炎 l 消化差 l 脾胃虚 人群研发的

不吃西药 不做艾灸 不动手术
每天午饭后喝一支,滋养脾胃5小时
驱胃寒、排胃毒,调脾养胃
消化增强不胀气,让胃更舒服
能正常吃东西

调理脾胃很重要
恢复肠道的消化功能
排出体内的有害物质
气血通畅,不显老

脾胃不虚,排湿排油
脾胃功能强,新陈代谢正常
啤酒肚、水肿腿慢慢不见了

没有胃毒、胃不上火,
口气清新了,没有口臭了
伴侣之间更亲密
同事之间无隔阂

喝丁香汇苓饮,脾好胃好,什么都好了
每天冲一杯,轻松养生
祛湿气、排胃毒、调脾养胃
不反酸、不胀气
正常饮食吸收好每盒12支
原价159一盒,现价49元两盒
买一发二盒(半周期)
买二发四盒!(一周期)
买4发12盒(三周期)(巨实惠)
比阿里健康大药房还便宜
抓紧下手
01
南京同仁堂出品,必是精品
国医馆是南京同仁堂旗下的茶饮品牌

02
传统中医研发与现代工艺结合
南京同仁堂黑科技——
低温破壁技术!
什么是低温破壁技术呢?
就是将中草药的活性成分
全部释放而出
喝的时候
只需开水简单冲泡
有效成分浸润而出,融入茶汤。
10斤的优质丁香、茯苓、山药、陈皮、麦芽、山楂、 荞麦,
才能提取出1斤的丁香汇苓饮。
留下的都是精华!
一支丁香汇苓饮=10包普通茶包

不管是居家生活还是上班办公,
随时随地都可以给自己泡上一杯
这样的养身茶。

这样的饮品喝下去,
进入脾胃,直达脾胃的中脘穴

不少人喝的当天就感觉肠胃
明显舒服了一些~

经常胃痛胃胀,说明胃已经开始“损坏”
西药治标不治本,老病根一直在
丁香汇苓饮通过药食同源来调理根本
从根源上帮你缓解
胃痛胃胀、脾不和、湿气重
03
纯中药提取物,都是精华!
精选道地中草药
将这7味道地原材:
丁香、茯苓、山药、陈皮、荞麦、麦芽、山楂
君臣佐使,发挥了更大的作用
直击胃病核心

丁香汇苓饮的第一大特色,
就是清细菌。
精选海南丁香,
安徽茯苓,
极大程度抑制幽门螺杆菌。

和传统胃药相比
丁香汇苓饮为药食同源配方
无副作用
其中的丁香油和丁香酚
能够抑制幽门杆菌的活性排除毒素
是肠胃有害菌的天敌!

一杯热腾腾的丁香汇苓饮喝下去,
慢慢温暖并舒缓胃部
祛除身体里的的湿寒阴冷
将脾胃变得温暖干燥,同时提升阳气
也令幽门螺旋杆菌无法繁殖
喝之前
体内环境阴冷潮湿

喝之后
体内环境温暖干燥有阳气

喝了一周后,
胃不适感减轻,饭后不痛不胀了
喝了两周后,
脾胃运化能力增强,消化速度变快
喝了四周后,
慢性胃炎好转,肠胃功能逐渐恢复健康
喝之前 喝之后

你会发现口腔内的口臭味会变淡不少,
口腔内的牙龈红肿、发炎,
口腔溃疡也能得到缓解。
基本饮用七天之后,
口腔内基本就不会再有异味,
就连舌根发苦、发干的现象也没有了。
试验出真知,丁香汇苓饮的杀菌测试
器皿中细菌含量逐步减少,
直到全部消失。
胃部有害细菌少了,口臭就大幅缓解
以前一米外都能闻见口臭
现在凑很近都闻不到一点点

非常臭的5级 现在一点都不臭了
04
易吸收,三天好转!
喝完大家都说好!
普通的养胃茶完全不能比!
两袋就能看到变化~
不胀气了!
排便通畅了!
口臭也少了!

除了健脾和胃,宁心安神
茯苓和陈皮还能去水肿
大部分中老年肥胖有一部分原因是因为水肿!
水肿消了,中老年高血压也会得到改善

△饮用一个月后对比图
喝了丁香汇苓饮之后,
你会发现腿一天一天的变细了,
水肿腿不见了!

脾胃功能提升后,排湿能力越加明显!
年轻朋友试喝会“莫名其妙”一下子掉好多赘肉

△小肚腩不见了!
丁香汇苓饮喝起来,脾好胃也好!
食欲大增,能祛湿吃不胖,
营养好了,气色好,心情好,啥都好了!
张小姐又年轻了
以前不懂事,经常暴饮暴食,
吃辣喝烫,结果把胃搞坏了。
多吃点有发胀,不但为胃胀气,还反酸疼痛,
脸色蜡黄且爆痘痘,补品吃了不吸收。
喝了一周丁香汇苓饮,
胃有一种舒展的感觉,
暖洋洋的,每天按时排便,
喝了半个月左右,胃胀气改善
气色大变样,简直换了个人!
不擦粉都白白嫩嫩!

一盒丁香汇苓饮,
会让你的肤色有提亮不少,
因为体内毒素积累长出的痘痘也会快速消掉。
皮肤的自我修复力也变的越來越好。
身体的毒火降了,
头发自然不会经常出油,
头皮上起的“火包”也逐渐消失,
一周不洗头头发也不会很油。

南京同仁堂丁香汇苓饮 | 去口臭,清虚火,养脾胃
买来除了自己喝,伴侣、好友都可以喝。中医有“元气不足,百病缠身”之说,意思是人体能够正常的运作,离不开元气的支持。每天喝一袋,毒素没了,皮肤好了,人也苗条了,好运都来啦!

写下你的想法